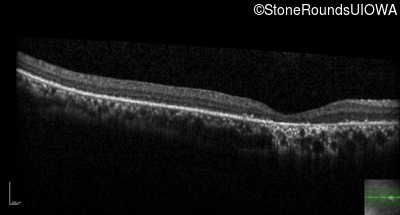
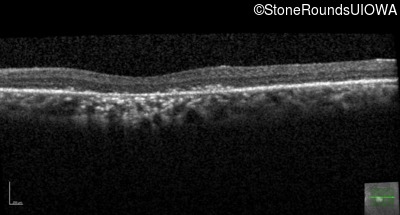
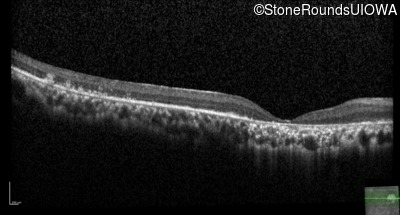
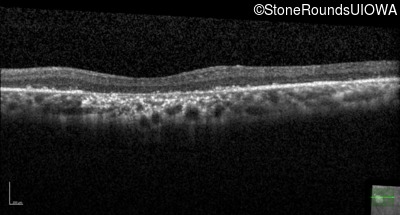
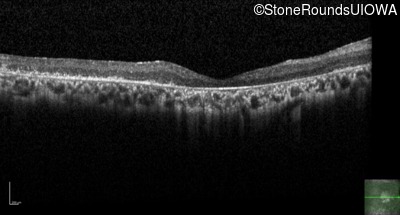
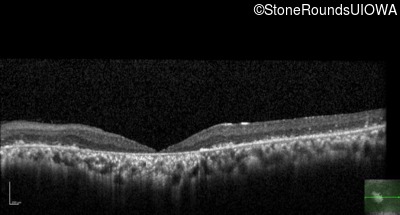

Case
SR1065
Student Mode
Bardet Biedl Syndrome (IB2)
Female
Female
Hidden
SR1065
Student Mode
Bardet Biedl Syndrome (IB2)
Female
Female
Highlighted Images
| Age at visit: 47 years | OD | OS |
|---|---|
History
This 47 year old woman was born with a supernumerary digit on the ulnar side of both hands. As a young child, her best corrected visual acuity was completely normal. She had no difficulties with her vision until age 30 when her visual acuity could no longer be corrected to 20/20 and she began to notice some night blindness.
| Refraction OD: | +1.00 |
|---|---|
| Refraction OS: | 1/1/1900 |
Teaching Points
The clinical features supporting the diagnosis of Bardet Biedl syndrome in this patient include: bone-spicule-like pigmentation, narrowed arterioles and macular atrophy on ophthalmoscopy; photoreceptor loss on OCT; ulnar polydactyly, obesity, abnormal cognition, hypertension; and, normally sighted parents.
| Age at visit: 44 years |
| Age at visit: 47 years |
| OD | OS | ||
|---|---|---|---|
| OD | OS | ||
|---|---|---|---|
| OD | OS | ||
|---|---|---|---|
| OD | OS | ||
|---|---|---|---|
| Age at visit: 49 years |
| OD | OS | ||
|---|---|---|---|
| OD | OS | ||
|---|---|---|---|
Diagnosis & molecular findings
| Disease | Gene | Allele 1 variant(s) | Allele 2 variant(s) | Inheritance mode |
|---|---|---|---|---|
| Bardet Biedl Syndrome | BBS1 | Met390Arg ATG>AGG | Met390Arg ATG>AGG | AR |
Disease:
Gene:
Allele 1:
Met390Arg ATG>AGG
Allele 2:
Met390Arg ATG>AGG
Inheritance:
AR